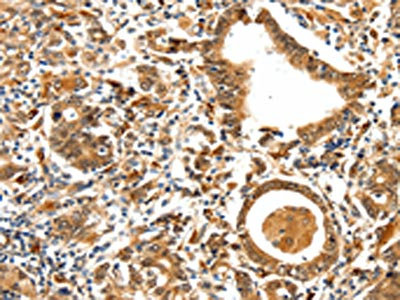

-
中文名稱:TPM2兔多克隆抗體
-
貨號:CSB-PA362939
-
規格:¥1100
-
圖片:
-
The image on the left is immunohistochemistry of paraffin-embedded Human ovarian cancer tissue using CSB-PA362939(TPM2 Antibody) at dilution 1/25, on the right is treated with synthetic peptide. (Original magnification: ×200)
-
The image on the left is immunohistochemistry of paraffin-embedded Human gastric cancer tissue using CSB-PA362939(TPM2 Antibody) at dilution 1/25, on the right is treated with synthetic peptide. (Original magnification: ×200)
-
Gel: 10%SDS-PAGE, Lysate: 40 μg, Lane: Mouse lung tissue, Primary antibody: CSB-PA362939(TPM2 Antibody) at dilution 1/450, Secondary antibody: Goat anti rabbit IgG at 1/8000 dilution, Exposure time: 2 minutes
-
-
其他:
產品詳情
-
Uniprot No.:
-
基因名:
-
別名:Alpha tropomyosin antibody; AMCD1 antibody; Arthrogryposis multiplex congenital distal type 1 antibody; Beta tropomyosin antibody; Beta-tropomyosin antibody; Cytoskeletal tropomyosin TM30 antibody; DA1 antibody; DA2B antibody; epididymis secretory protein Li 273 antibody; FLJ41118 antibody; Heat stable cytoskeletal protein 30 kDa antibody; HEL-S-273 antibody; hscp30 antibody; HTM alpha antibody; hTM5 antibody; MGC14582 antibody; MGC3261 antibody; MGC72094 antibody; NEM1 antibody; NEM4 antibody; Nemaline myopathy type 4 antibody; OK/SW cl.5 antibody; Sarcomeric tropomyosin kappa antibody; TM 5 antibody; TM3 antibody; TM30 antibody; TM30nm antibody; TMSA antibody; TMSB antibody; TPM 1 antibody; TPM 3 antibody; TPM1 alpha antibody; TPM1 kappa antibody; TPM2 antibody; TPM2_HUMAN antibody; TRK antibody; Tropomyosin 1 alpha antibody; Tropomyosin 1 alpha chain antibody; Tropomyosin 1 alpha chain isoform 6 antibody; Tropomyosin 2 (beta) antibody; Tropomyosin 2 antibody; Tropomyosin 3 antibody; Tropomyosin alpha 3 chain antibody; Tropomyosin alpha striated muscle isoform antibody; Tropomyosin beta chain antibody; Tropomyosin gamma antibody; Tropomyosin skeletal muscle beta antibody; Tropomyosin-2 antibody
-
宿主:Rabbit
-
反應種屬:Human,Mouse,Rat
-
免疫原:Synthetic peptide of Human TPM2
-
免疫原種屬:Homo sapiens (Human)
-
標記方式:Non-conjugated
-
抗體亞型:IgG
-
純化方式:Antigen affinity purification
-
濃度:It differs from different batches. Please contact us to confirm it.
-
保存緩沖液:-20°C, pH7.4 PBS, 0.05% NaN3, 40% Glycerol
-
產品提供形式:Liquid
-
應用范圍:ELISA,WB,IHC
-
推薦稀釋比:
Application Recommended Dilution ELISA 1:1000-1:5000 WB 1:200-1:1000 IHC 1:25-1:100 -
Protocols:
-
儲存條件:Upon receipt, store at -20°C or -80°C. Avoid repeated freeze.
-
貨期:Basically, we can dispatch the products out in 1-3 working days after receiving your orders. Delivery time maybe differs from different purchasing way or location, please kindly consult your local distributors for specific delivery time.
-
用途:For Research Use Only. Not for use in diagnostic or therapeutic procedures.
相關產品
靶點詳情
-
功能:Binds to actin filaments in muscle and non-muscle cells. Plays a central role, in association with the troponin complex, in the calcium dependent regulation of vertebrate striated muscle contraction. Smooth muscle contraction is regulated by interaction with caldesmon. In non-muscle cells is implicated in stabilizing cytoskeleton actin filaments. The non-muscle isoform may have a role in agonist-mediated receptor internalization.
-
基因功能參考文獻:
- Hypoxia may regulate cell invasiveness partly by TPM2 down-regulation mediated changes of MMP2 expression, which is also a new pathway by which hypoxia regulates cancer progression. TPM2 is a potential novel tumour suppressor gene in breast cancer. PMID: 29414807
- The increased expression of TPM1lambda and the decreased expression of TPM1delta RNA and TPM2beta may lead to decreased stress fiber formation and malignant transformation in human breast epithelial cells. PMID: 27108600
- TPM2 appears to be commonly silenced by aberrant DNA methylation in colon cancer. TPM2 loss is associated with RhoA activation and tumor proliferation. PMID: 27333992
- Despite its reduced affinity for actin in co-sedimentation assay, the Q147P mutant incorporates into the muscle fiber ..Q147P tropomyosin (TPM2)binds to actin in ghost muscle fiber. PMID: 26708479
- tropomyosin 2.1 acts as a suppressor of growth on soft matrices by supporting proper rigidity sensing PMID: 26619148
- Myo1c significantly increases the frequency of kinesin-1-driven microtubule-based runs that begin at actin/microtubule intersections. The actin-binding protein tropomyosin 2 abolishes Myo1c-specific effects on both run initiation and run termination. PMID: 25660542
- Patients with TPM2 mutations tended to present with milder symptoms than those with TPM3 mutations, DA being present only in the TPM2 group. PMID: 24692096
- in a cohort of 94 patients with congenital myopathy, 2 related female patients and 2 sporadic male patients were found to carry mutations in TPM2 and TPM3 genes respectively; clinical presentation and muscle morphological findings differed in the patients PMID: 24507666
- Histopathological phenotype association of muscle fibers expressing Beta-tropomyosin mutational variants that occur in human myopathies. PMID: 24039757
- effect of the skeletal myopathy-causing E117K mutation in human beta-tropomyosin on actomyosin structure during the ATPase cycle PMID: 24657080
- We showed that TPM2, CLU, and COL4A6 mRNA levels are downregulated in prostate cancer. PMID: 23621580
- The p.R133W mutation in TPM2 is associated with Sheldon-Hall syndrome. PMID: 23678273
- The E117K mutation in tropomyosin beta chain that causes nemaline myopathy shifts the tropomyosin strands to the closed position and suppresses their conformational rearrangements on the thin filament. PMID: 23689010
- expanding the spectrum of TPM2 myopathies to very mild patients who could still be pathologically recognized by the presence of cap structures PMID: 23015096
- Novel de novo missense mutations in TPM2 were found to be associated with marked fibre size disproportion in two patients with congenital fibre type disproportion. PMID: 22832343
- The TPM2-null mutations decreased cooperative thin filament activation in combination with reductions in the myosin cross-bridge number and force production PMID: 22798622
- distal arthrogryposis syndromes associated with TPM2 mutations include the less severe forms[review] PMID: 22749895
- A novel beta-tropomyosin mutation is described that is associated with two clinical-histopathological phenotypes not previously associated with it. PMID: 23413262
- p.K7del is a common hetreozygous recurrent TPM2 mutation associated with nemaline myopathy. PMID: 23378224
- This study demonistrated that most patients with TPM2 mutations show a predominant involvement of masticatory and distal leg muscles with the other regions relatively spared. PMID: 22980765
- actin binding was weak in three of five mutants suggesting that abnormal binding between actin and aberrant Tm is the pathogenetic mechanism causing muscle weakness in patients with nemaline and cap myopathy. PMID: 22084935
- in cells expressing R133W beta-tropomyosin mutation, during activation, switching of positive to neutral charge at position 133 partially hinders calcium- and myosin-induced tropomyosin movement over the thin filament blocking actin conformation change PMID: 20457903
- While demonstrating suppressed levels of Tm1 in the prostate cancer cell lines LNCaP, PC3, and DU-145 compared to normal prostate epithelial cell primary isolates, a novel splice variant of the TPM2 gene was identified. PMID: 20336778
- Tropomyosin 2 plays a role in growth and metastasis of hepatic tumors. PMID: 18246790
- beta-tropomyosin exon 6B splicing requires hnRNP A1 and ASF/SF2 and SC35 PMID: 15208309
- We describe two patients, a woman and her daughter, with muscle weakness and distal arthrogryposis (DA) type 2B, caused by a heterozygous missense mutation, R133W. PMID: 17339586
- R133W beta-Tm mutation induces alterations in myosin-actin kinetics causing a reduced number of myosin molecules in the strong actin-binding state, resulting in overall muscle weakness in the absence of muscle wasting. PMID: 17430991
- results indicate that mutations in TPM2 may cause nemaline myopathy as well as cap disease with a dominant mode of inheritance; these disorders may thus be phenotypic variants of the same genetic defect PMID: 17846275
- beta-TM gene mutations can alter the expression of other sarcomeric TM isoforms PMID: 18422639
- Mutations in TPM2 seem to be a frequent cause of cap disease. PMID: 19047562
- This first report of the clinical expression of the complete absence of TPM2 in human indicated that TPM2 expression at the early period of prenatal life plays a major role for normal fetal movements. PMID: 19155175
- The destabilizing effect of the disease-causing arginine91glycine mutation spreads along the coiled-coil, reflecting the high extent of cooperativity within this part of the beta-tropomyosin molecule. [review] PMID: 19214762
- Our patient has an identical TPM2 mutation to the first genetically diagnosed cap disease patient, a denovo heterozygous three base pair deletion that removes glutamic acid 139 from the centre of beta-tropomyosin. PMID: 19345583
顯示更多
收起更多
-
相關疾病:Nemaline myopathy 4 (NEM4); Arthrogryposis, distal, 1A (DA1A); Cap myopathy 2 (CAPM2); Arthrogryposis, distal, 2B (DA2B)
-
亞細胞定位:Cytoplasm, cytoskeleton.
-
蛋白家族:Tropomyosin family
-
組織特異性:Present in primary breast cancer tissue, absent from normal breast tissue.
-
數據庫鏈接:
Most popular with customers
-
-
YWHAB Recombinant Monoclonal Antibody
Applications: ELISA, WB, IHC, IF, FC
Species Reactivity: Human, Mouse, Rat
-
Phospho-YAP1 (S127) Recombinant Monoclonal Antibody
Applications: ELISA, WB, IHC
Species Reactivity: Human
-
-
-
-
-